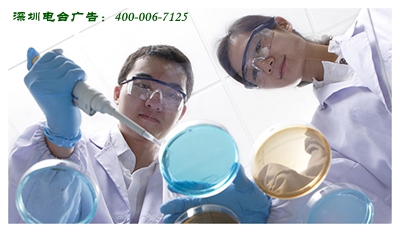

来源:广视通广告 时间:2015-12-15 16:52:56
一,重新定义节目类型
目前专题广告有5分钟、8分钟、20分钟、40分钟、45分钟、50分钟、60分钟、100分钟等几个规格,除了5分钟和8分钟之外,建议其他规格的专题广告全部重新定义节目类型,将其打造为多种类型的、面向中老年的节目。
根据每一种产品的特性与功效,为其设定一个恰当的节目类型, 在节目编排上,吸收“类型化”编排的优势——“碎片化”,将长专题广告切分为短专题和品牌硬广告,并与其他类型的节目素材进行编排、实现较好的收听效果。
.png)
二、增加硬广告回报:
对于专题客户而言,转型是痛苦的过程,为了尽可能让专题客户不流失,建议如下:
为广告量特别大的专题客户设计其他频率的硬广回报,增加客户满意度和广告效果。具体为:在一些相对弱势的调频频率的不饱和时间段,为专题客户的产品投播一些10秒的节目宣传,例如在其他频率的广告不饱和时段,每天8次播出10秒硬广为了调动频率的积极性,可以洽谈一个较低的广告折扣,按次数向频率支付广告费,这样也盘活了调频频率不饱和广告时段。
三、节目创新和盘活节目资源的角度:
通过医药专题广告节目的转型,可以研发出更多面向中老年听众的节目形态。例如:
1. 情感类节目。可以将类似叶文有话说这样的栏目进行剪辑,打造成《情感热线》节目,由某某口服液冠名播出,每通电话剪辑成5分钟左右,与产品短专题和硬广编排,这样做收听率应该很不错。这样,也是将节目进行二次剪辑和播出利用,提升了资源利用率,盘活整体节目资源。
2. 娱乐段子类节目。比如把幽默小段子制作成多个5分钟的小单元,打造一档《段子串串秀》节目,与产品短专题和硬广编排。

四、需与医药专题广告客户协调的问题
1. 每小时4档广告小单元时间虽短,但还是需要与客户的团队进行策划与讨论,主要是如何在5分钟内,从 “认同、理解、认知、行动”的经典4步结构来规划嘉宾讲解内容、切入点和反馈热线等。
2. 整体节目和硬广告回报方案的确认。
3. 嘉宾讲师团队的资质问题,需要具有相关行业从业资质。
24小时客户服务热线:如果你对以上深圳广播电台广告投放感兴趣,请点击联系我们网页右侧的在线客服,或致电 0755-82903320,广视通广告--您的广播广告投放顾问。

全国广播电台广告网 2008-2023 版权所有
地 址:深圳市福田区红荔西路天健名苑B座31层
Copyright 2008 - 2022 www.gstad.com.cn Corporation, All Rights Reserved
深圳广告公司联系电话:133-1651-4119
E-mail:64590423@qq.com